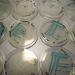

Becky Bracken

Becky is a self-confessed food freak, news junkie, policy nerd and ravenous gossip hound and covers food safety and public policy for Foodista.com. Becky is a media veteran with a food specialty and has written for radio, television, print and online media. Recently, she launched her own food, news and celebrity site, FoodieGaga.com.